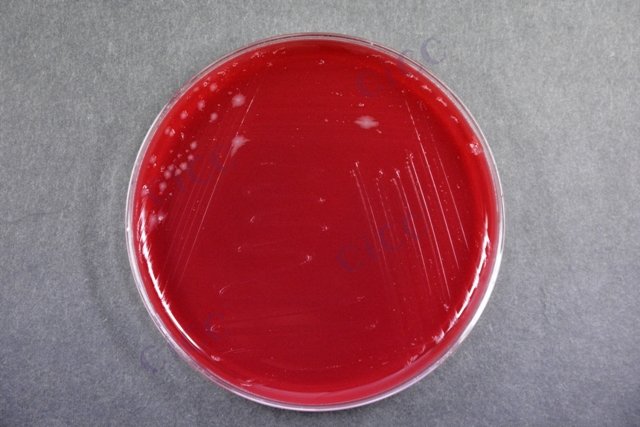
艰难梭菌 Clostridium difficile CICC 22951 Clostridium difficile

艰难梭菌 Clostridium difficile CICC 22951 Clostridium difficile
-
艰难梭菌 Clostridium difficile CICC 25028 Clostridium difficile
CICC 25028 | 见证书
-
艰难梭菌 1351 Clostridium difficile (Hall and O'Toole) Prevot
BNCC344673 | 冻干粉;菌液;平板
-
艰难梭菌 545 Clostridium difficile (Hall and OToole) Prevot
BNCC244976 | 平板
-
艰难拟梭菌 Clostridioides difficile ATCC 43255 Culti-Loop Clostridium difficile ATCC 43255
R4601603 | 5支/包
-
艰难拟梭菌 Clostridioides difficile ATCC 700057 Culti-Loop Clostridium difficile ATCC 700057
R4609452 | 5支/包
-
Culti-Loop艰难拟梭菌 Clostridium difficile ATCC BAA-1870
R4609433 | 5支/包
-
Culti-Loop艰难拟梭菌 Clostridium difficile ATCC BAA-1870
R4609434 | 5支/包

说明书下载: 菌种说明书 打管说明书
您正在浏览的产品:艰难梭菌 Clostridium difficile CICC 22951
手机版:艰难梭菌 Clostridium difficile CICC 22951
本公司销售的所有产品仅供实验科研使用,不用于人体及临床诊断。
2. 核酸扩增试验(NAAT)检测毒素基因(tcdA/tcdB/cdtB)
3. 谷氨酸脱氢酶(GDH)联合毒素A/B免疫层析法[9][2]
2. GDH检测灵敏度>95%,毒素A/B检测灵敏度约60-75%[9][7]
2. 每批次检测须包含阴性质控(无菌生理盐水)和阳性质控[9]
2. DNA提取采用磁珠法或煮沸法
3. PCR扩增参数:预变性95℃ 5min,40个循环(95℃ 30s,60℃ 30s,72℃ 30s)[9][7]
2. 毒素检测阴性但NAAT阳性者需结合内镜检查
3. 暴发流行时需增加二元毒素(CDT)基因检测[9][4]
2. 厌氧培养条件:37℃、80%N₂+10%H₂+10%CO₂环境培养48小时[8][4]
2. 厌氧环境指示剂需每日监测[8]
2. 接种后48小时观察菌落,辅以革兰染色(紫蓝色杆菌带芽孢)
3. 毒素检测前需进行次代纯培养[8][4]
2. 实验室需建立生物安全二级(BSL-2)操作规范[8][9]
2. 厌氧培养后PCR验证tcdB基因[3]
2. 采用改良PYG液体培养基增菌[3]
以上信息仅供参考,请以相应标准的原文为准!